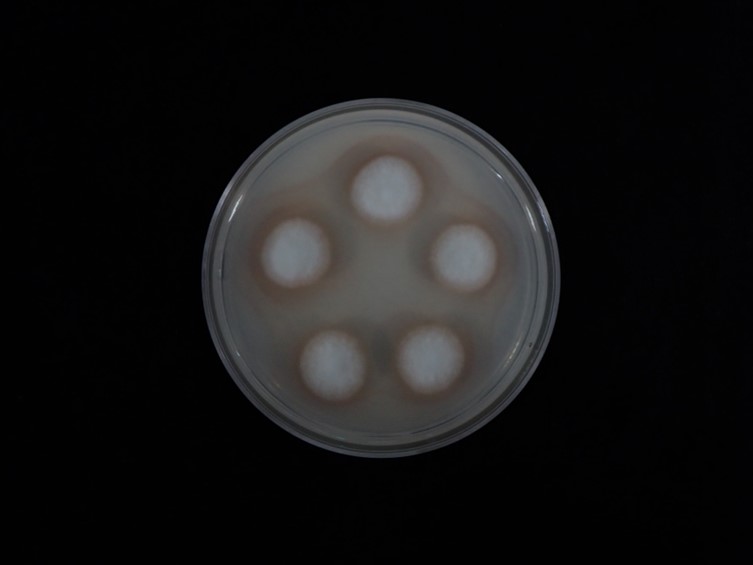

Holotype:
THAILAND, Chumphon Province, Phato Watershed Conservation and Management Unit, 10 March 2010, K. Tasanathai, P. Srikitikulchai, A. Khonsanit, K. Sansatchanon, D. Thanakitpipattana, holotype BBH 31245, ex-type living culture BCC 47541.
Habitat:
Underside of of bamboo leaves.
Host:
On spider eggs sac (Araneidae sensu lato)
Description:
 Perithecia produced on the mycelial mat covering the body of the hosts, superficial with mycelia covering the bottom half of the perithecium, ovoid narrowing towards the ostiole, 500–660 × 280–380 μm.
Perithecia produced on the mycelial mat covering the body of the hosts, superficial with mycelia covering the bottom half of the perithecium, ovoid narrowing towards the ostiole, 500–660 × 280–380 μm.  Asci cylindrical, 100–400 × 3–5 μm, with cap 2–3 μm thick. Ascospores hyaline, filiform, whole ascospores, extending the length of ascus. Synnema produced from the host, erect, unbranched, solitary, cylindrical, 5–8 mm long, ca. 0.5 mm wide. Conidiophores produced along the synnema, on the mycelium covering the hosts.
Asci cylindrical, 100–400 × 3–5 μm, with cap 2–3 μm thick. Ascospores hyaline, filiform, whole ascospores, extending the length of ascus. Synnema produced from the host, erect, unbranched, solitary, cylindrical, 5–8 mm long, ca. 0.5 mm wide. Conidiophores produced along the synnema, on the mycelium covering the hosts.  Phialides consisting of a cylindrical basal portion, verticillate, with phialides in whorls of two to five, occasionally with solitary phialides, 8–15 × 1–2.5 μm, tapering into a distinct slightly curved neck, 3–8 × 1–1.5 μm.
Phialides consisting of a cylindrical basal portion, verticillate, with phialides in whorls of two to five, occasionally with solitary phialides, 8–15 × 1–2.5 μm, tapering into a distinct slightly curved neck, 3–8 × 1–1.5 μm.  Conidia fusiform, slightly curved, aggregated at the apex of the phialides, 4–5 × 1–2 μm.
Conidia fusiform, slightly curved, aggregated at the apex of the phialides, 4–5 × 1–2 μm.
Culture characteristics:
Colonies on PDA attaining a diam of 10–15 mm in 14 days, cottony with high mycelium density, white, reverse moderate yellowish pink, producing reddish pigment diffusing in agar medium. Phialides arising from vegetative hyphae, solitary, narrow cylindrical basal portion, 10–50 × 0.5–2 μm. Conidia hyaline, smooth, aggregated at the apex of the phialides, distinctly of two types: 1) cylindrical, aseptate, 3–8 × 1.5–2 μm; 2) fusiform, early in development aseptate, becoming 1 septum, 10–18 × 2–3 μm, aggregated at the apex of the phialides. Conidial arrangement acremonium-like. Microcycle conidiation observed, cylindrical 2–5 × 1–2 μm.
Colonies on PDA attaining a diam of 10–15 mm in 14 days, cottony with high mycelium density, white, reverse moderate yellowish pink, producing reddish pigment diffusing in agar medium. Phialides arising from vegetative hyphae, solitary, narrow cylindrical basal portion, 10–50 × 0.5–2 μm. Conidia hyaline, smooth, aggregated at the apex of the phialides, distinctly of two types: 1) cylindrical, aseptate, 3–8 × 1.5–2 μm; 2) fusiform, early in development aseptate, becoming 1 septum, 10–18 × 2–3 μm, aggregated at the apex of the phialides. Conidial arrangement acremonium-like. Microcycle conidiation observed, cylindrical 2–5 × 1–2 μm.
Reference:
Mongkolsamrit S, Sandargo B, Ebada SS, et al. (2023). Bhushaniella gen. nov. (Cordycipitaceae) on spider eggs sac: a new genus from Thailand and its bioactive secondary metabolites. Mycological Progress22: 64.
DOI: https://doi.org/10.1007/s11557-023-01915-3Species |
Strain |
Compound |
Pubchem CID |
Biological activity |
Reference |
|---|
|
Strain |
OQ892127 | OQ892128 | OQ892129 |
|---|---|---|---|
| BCC 47515 | OQ892132 | - | - |
| BCC 47541 | - | OQ892133 | - |
| BCC 47542 | - | - | OQ892134 |